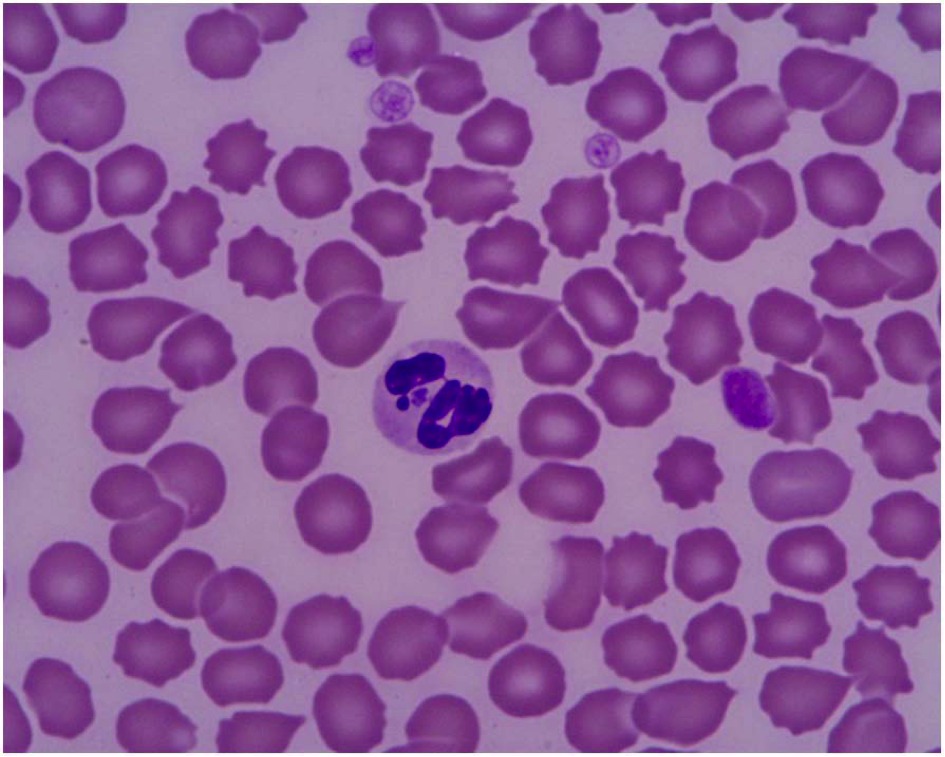

10 octobre 2025
 5 min
5 min

Bienvenue sur LeFil.vet
L'accès au site web nécessite d'être identifié.
Merci de saisir vos identifiants de connexion.
Indiquez votre email dans le champ ci-dessous.
Vous recevrez un email avec vos identifiants de connexion.


6 février 2015
Consensus sur l’ehrlichiose et l’anaplasmose canines en Europe
De nouvelles recommandations pratiques vétérinaires sur ces maladies vectorielles viennent d’être publiées par un consortium d’experts.
Diagnostiquer, traiter et prévenir l’ehrlichiose et l’anaplasmose canines : de nouvelles recommandations pratiques viennent d’être publiées par un consortium d’experts. Elles se présentent sous la forme de questions-réponses, à l’intention des praticiens vétérinaires d’Europe.
La publication, mise en ligne le 4 février, est disponible en libre accès (en anglais).
Les 29 questions posées, et leurs réponses, balayent en 18 pages tous les aspects des deux maladies : étiologie, transmission, épidémiologie, signes cliniques, examens complémentaires (analyses de laboratoire), diagnostic, traitement et prophylaxie.
On peut lire par exemple que le pronostic de l’ehrlichiose est moins bon chez le berger allemand et le husky, dont l’atteinte clinique est plus grave que dans d’autres races. Les signes cliniques, variables selon l’animal, la souche du parasite et d’éventuelles co-infections, sont non spécifiques et généralement plus marqués que ceux de l’anaplasmose.
Le diagnostic direct, par l’observation des parasites au microscope à partir d’un prélèvement de sang, est plus fréquent pour l’anaplasmose que pour l’ehrlichiose (diagnostic positif dans 60 % des cas cliniques contre 4 à 6 %). Mais l’identification de l’espèce est malaisée et une confirmation par analyse PCR est requise (sur échantillon de sang sur tube EDTA).
Le traitement de choix de l’ehrlichiose est la doxycycline à la dose de 10 mg/kg/jour (en une à deux prises). Une durée de traitement d’au moins quatre semaines est recommandée, afin d’éviter la persistance de la maladie, sous forme chronique subclinique. La guérison est obtenue dans la majorité des cas.
La recommandation de traitement pour l’anaplasmose est moins précise (doxycycline à la même posologie durant deux à trois semaines) ; elle manque de données.
L’association de l’antibiotique à un glucocorticoïde n’est pas recommandée d’emblée. Elle s’envisage en cas d’échec de l’antibiothérapie.
Les réinfections sont possibles, au moins pour l’ehrlichiose. Et la prophylaxie se limite aujourd’hui à la prévention des morsures des tiques vecteurs. Des études sont toutefois en cours pour le développement d’un vaccin contre l’ehrlichiose.
Le consortium signataire comprend cinq membres d’un groupe d’experts espagnol (ENTRA), soutenu par le laboratoire Merial, mais revendiquant son indépendance scientifique.
La prévalence des deux maladies chez le chien reste limitée en France (0,3% pour Ehrlichia canis et 2,7% pour Anaplasma phagocytophilum). Mais l’évolution des populations de tiques vecteurs (Rhipicephalus sanguineus et Ixodes ricinus, respectivement) et l’extension de leur distribution géographique en Europe laissent craindre une augmentation.
Distribution géographique d’Ixodes ricinus en Europe, d’après l’ECDC (European Centre for Disease Prevention and Control), octobre 2014.

10 octobre 2025
 5 min
5 min

9 octobre 2025
 3 min
3 min

8 octobre 2025
 4 min
4 min

7 octobre 2025
 4 min
4 min

6 octobre 2025
 4 min
4 min

3 octobre 2025
 3 min
3 min
